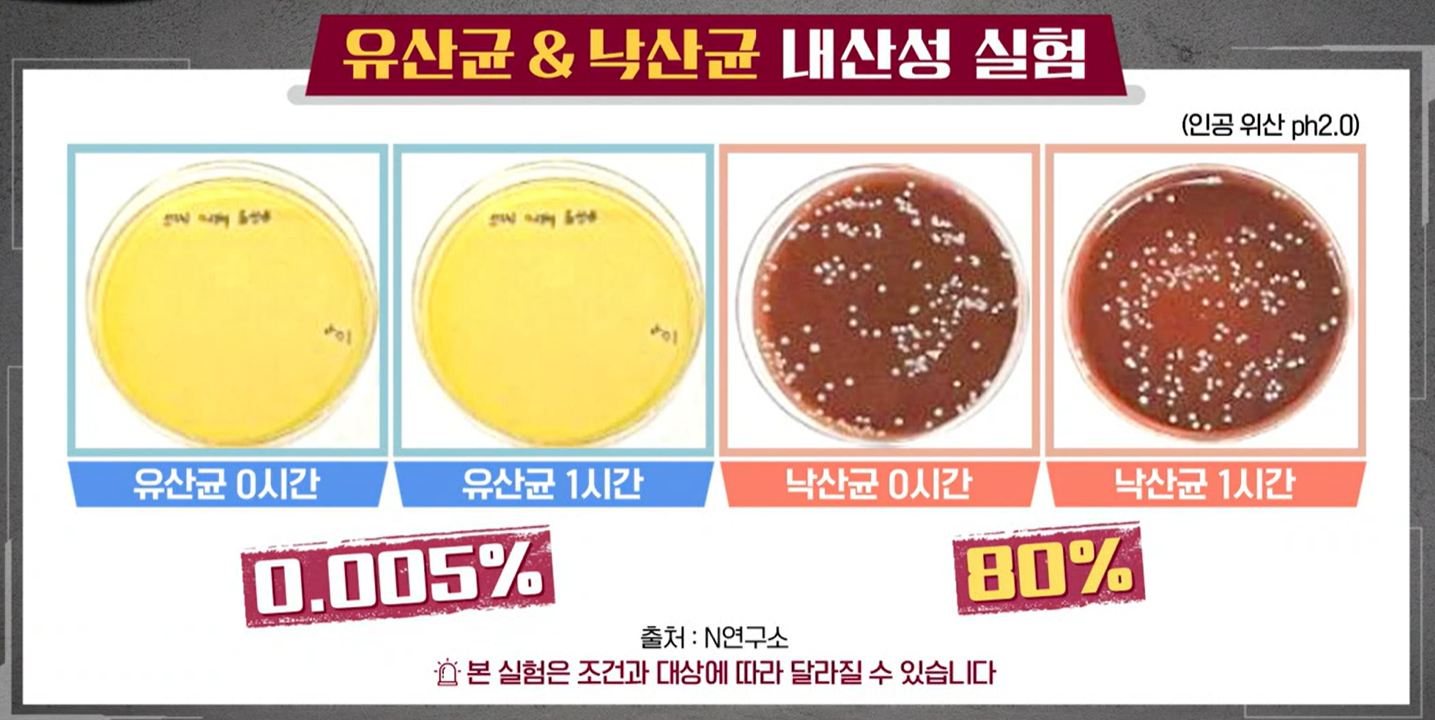
낙산균효능

티스토리 뷰
낙산균이란, 프로바이오틱스 효능, 부작용, 가격, 복용법 정리해 드리겠습니다.
1. 낙산이란?

우리 몸은 탄수화물, 단백질, 지방을 주 에너지원으로 사용합니다. 그중에서도 탄수화물을 포도당으로 변환시켜 가장 많이 사용하는데 대장 세포에서는 포도당을 에너지원으로 사용하지 않고 낙산이라는 것을 에너지원으로 사용합니다.


낙산이란 단쇄지방산의 일종으로 장의 산성 농도를 맞춰 장 내 면역력을 높이는 역할을 합니다. 단쇄지방산 중에서도 대장 세포의 먹이 역할을 하는 낙산은 장내 미생물이 식이섬유를 분해할 때 생성됩니다. 때문에 고기 같은 육류보다는 채소를 많이 섭취해야 생성됩니다.

대장에는 체내 면역 세포의 70%가 존재하고 있는데 낙산이 부족하면 제대로 된 대장 세포 기능을 하기 어렵습니다. 대장 세포의 먹이인 낙산이 부족하면 대장의 용종, 선종은 물론 만성 변비까지 생길 수 있습니다. 또한 대장의 면역력이 저하되어 대상포진, 구내염, 감기 등에 노출기 쉽습니다.
낙산을 보충하기 위해서는 채소 같은 일반적인 식이섬유로는 부족할 수 있습니다. 때문에 낙산을 생성하는 균의 형태로 보충하는 방법을 권장드립니다.

일명 낙산균이라는 것인데 일본에서는 이미 1930년대부터 대장 건강에 자주 활용되고 있습니다. 낙산균은 낙산 자체를 생성하는 균이기 때문에 가장 직접적으로 낙산을 생성하는데 효능이 있는 것으로 알려져 있습니다.
가장 진화된 형태의 프로바이오틱스, 방탄 프로바이오틱이라는 별명을 가진 낙산균은 일반적인 유산균의 단점을 보완한 유산균으로 다양한 효능을 가지고 있습니다.
2. 낙산균 효능
1) 위산에 강함
일반적인 유산균은 소장까지 도달하고 사멸되어 대장까지는 도달하지 못합니다. 소장까지 도달하는 유산균도 인위적인 캡슐을 씌워 위산에 녹지 않게 만들었기 때문에 가능합니다. 하지만 낙산균은 균 자체에 강력한 보호막이 존재합니다.


낙산균에는 아포라는 4가지 보호막이 있습니다. 포자 외피, 아포각, 세포 외막, 아포 피질이라는 4겹의 보호막은 각기 수행 능력이 다릅니다. 4겹의 갑옷은 아주 강력하게 위산이나 담즙을 막아냅니다.
내산성 인공 위산을 준비해서 유산균과 낙산균의 변화를 확인한 결과 1시간 후 유산균은 0.005%가 살아남았지만 낙산균은 80%나 살아남았다는 연구 결과가 있습니다.
2) 열에 강함
유산균은 열에 약해서 뜨거운 물과 함께 복용하면 좋지 않습니다. 반면에 낙산균은 열에 강해서 뜨거운 물과 함께 섭취해도 상관이 없다고 합니다.

실제로 낙산균과 유산균을 2시간 동안 60도에서 열처리를 진행한 결과 2시간 뒤 유산균은 0.006%가 살아남았지만 낙산균은 90%가 생존했다는 보고가 있습니다.
3) 무산소에 강함



우리 몸속 대장 환경은 산소가 거의 없는 상태입니다. 대부분의 유산균은 산소가 있어야 생존이 가능해서 산소가 있는 소장까지만 생존이 가능합니다.
소장 내 유산균은 전체 미생물 중 6% 정도가 있지만 대장에서는 전체 미생물 중 0.3%만 있을 정도로 산소의 영향이 중요합니다.
하지만 낙산균은 산소가 없는 곳에서도 생존하기 때문에 대장에서 불사조처럼 생존할 수 있습니다.
4) 장벽 기능 강화 효능


때문에 장 내 단쇄지방산 수치가 낮다면 꾸준한 낙산균 섭취를 권장드립니다. 꾸준한 낙산균의 섭취는 장 점막층의 두께를 증가시켜 장벽 기능 강화에 도움이 되기 때문입니다.
낙산균으로 장 점막이 강화되면 대장 종양 세포의 증식을 억제하고 종양 세포의 사멸을 촉진해 대장암을 예방하는데 효능이 있는 것으로 알려져 있습니다.
5) 염증 완화 효능

낙산균은 대장에서 발생하는 염증성 질환인 궤양성 대장염에도 효능이 있는 것으로 알려져 있습니다.
실제로 궤양성 대장염 환자 17명을 대상으로 9주간 낙산균을 섭취하게 한 결과 대조군에 비해 증상 개선 및 장내 세균총이 안정화되었다는 연구 과가 있습니다.
또한 대표적인 만성 염증 질환인 크론병 환자 13명에게 8주간 낙산 4g을 섭취하게 했더니 증상이 완화되고 내시경 및 조직학적 점수가 개선되었다는 보고가 있습니다.


3. 낙산균 부작용 및 섭취 방법



낙산균은 하루 섭취 권장량 200mg으로 4,000만 CFU 정도를 권장드립니다. 낙산균을 과다 복용 시 설사, 복통 등과 같은 부작용 있을 수 있으니 주의하는 것이 좋습니다.
또한 낙산균 섭취 시 특이체질이나 임산부의 경우 전문의와 상의 후 복용하는 것을 권장드립니다.
낙산균은 되도록이면 위산 활동이 적은 공복에 미지근한 물과 함께 섭취하는 것이 좋습니다.
4. 낙산균 가격

온라인쇼핑몰에서 판매되는 낙산균 가격은 보통 1만 원~3만 원대로 형성되어 있는 것으로 확인됩니다.
낙산균을 고를 때에는 균수보다 낙산균이 들어있는지 꼭 확인하는 것이 좋습니다. 아무리 많은 유산균을 섭취한다 해도 대장까지 살아남지 못하면 의미가 없기 때문입니다.
'건강 정보' 카테고리의 다른 글
| bnr17유산균 효능, 부작용, 복용법, 가격비교, 추천 (0) | 2023.05.20 |
|---|---|
| 카무트 효소 분말 효능, 가격, 부작용, 고르는 법 정리 (1) | 2023.05.19 |
| 아틱오트베타글루칸 효능, 부작용, 복용법 정리 (0) | 2023.05.17 |
| 산양유단백질 효능, 부작용 정리 (0) | 2023.05.17 |
| 배란일 계산기, 가임기 계산법, 배란일 증상, 확인 방법 정리 (0) | 2023.05.07 |